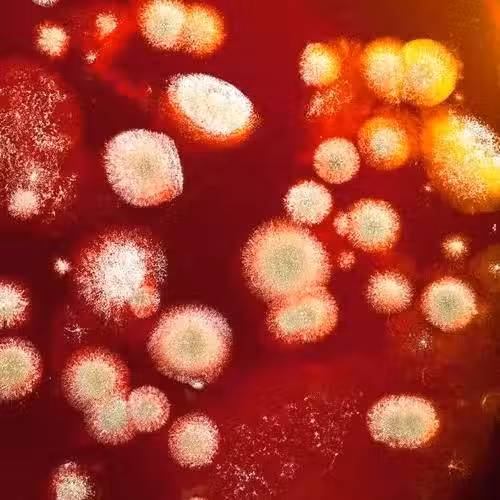

4/4
下一頁
長期吃這種食用油竟易誘發肝癌?提醒:購買食用油需牢記這些事!
4/4
總而言之,導致患上肝癌的原因較多,但是,與食用一些發霉、變質的食物有很大關係,比如滋生出大量黃麴黴毒素的花生油。
所以在購買花生油時,一定要購買正規廠商生產的花生油,並且,不要一次性大量購買,花生油的保質期只有18個月,沒有開封過的花生油在通風、涼爽的環境中,最多只能保存兩年。
另外,花生油一旦開封,氧化的速度會非常快,不但會使花生油的口感變差,還會滋生大量黃麴黴毒素,對於肝臟健康危害非常大。
所以在購買花生油時,一定要購買正規廠商生產的花生油,並且,不要一次性大量購買,花生油的保質期只有18個月,沒有開封過的花生油在通風、涼爽的環境中,最多只能保存兩年。
另外,花生油一旦開封,氧化的速度會非常快,不但會使花生油的口感變差,還會滋生大量黃麴黴毒素,對於肝臟健康危害非常大。
 呂純弘 • 13K次觀看
呂純弘 • 13K次觀看 幸山輪 • 500次觀看
幸山輪 • 500次觀看 幸山輪 • 850次觀看
幸山輪 • 850次觀看 花伊風 • 470次觀看
花伊風 • 470次觀看 幸山輪 • 400次觀看
幸山輪 • 400次觀看 幸山輪 • 580次觀看
幸山輪 • 580次觀看 喬峰傳 • 260次觀看
喬峰傳 • 260次觀看 花伊風 • 200次觀看
花伊風 • 200次觀看 一條毛 • 100次觀看
一條毛 • 100次觀看 幸山輪 • 300次觀看
幸山輪 • 300次觀看 幸山輪 • 120次觀看
幸山輪 • 120次觀看 幸山輪 • 120次觀看
幸山輪 • 120次觀看 呂純弘 • 320次觀看
呂純弘 • 320次觀看 游啊游 • 250次觀看
游啊游 • 250次觀看 喬峰傳 • 270次觀看
喬峰傳 • 270次觀看 幸山輪 • 130次觀看
幸山輪 • 130次觀看 幸山輪 • 130次觀看
幸山輪 • 130次觀看 幸山輪 • 490次觀看
幸山輪 • 490次觀看 幸山輪 • 10次觀看
幸山輪 • 10次觀看 幸山輪 • 30次觀看
幸山輪 • 30次觀看 幸山輪 • 40次觀看
幸山輪 • 40次觀看 幸山輪 • 70次觀看
幸山輪 • 70次觀看 花伊風 • 180次觀看
花伊風 • 180次觀看





















